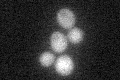
YPL152W
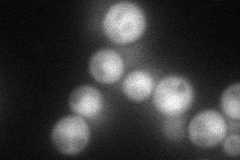
YPL152W
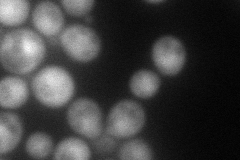
YPL152W
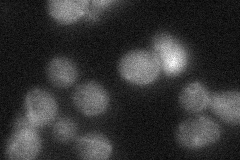
YPL152W
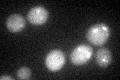
YPL152W
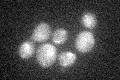
YPL152W

View description
Activator of the phosphotyrosyl phosphatase activity of PP2A,peptidyl-prolyl cis/trans-isomerase; regulates G1 phase progression, the osmoresponse, microtubule dynamics; subunit of the Tap42p-Pph21p-Rrd2p complex
Localization:
Intensity:
Fold change:
Significance:
-
C’ GFP library in SD
cytosol20.96 -
N' NOP1pr-GFP in SD
cytosol71.0905 -
N' TEF2pr-mCherry in SD
nucleus86.8276 -
N' NATIVEpr-GFP in SD
cytosol26.9883 -
N' TEF2pr-VC and Cyto-VN in SD

#N/A0 -
C’ GFP library in SD+DTT
cytosol21.531.02No -
C’ GFP library in SD+H2O2
cytosol24.911.18No -
C’ GFP library in Starvation Media

cytosol38.611.84No -
C’ GFP library on the background of Pup2-DaMP

cytosol -
C’ GFP library on the background of CCT mutant

cytosol23.47191.11935No
